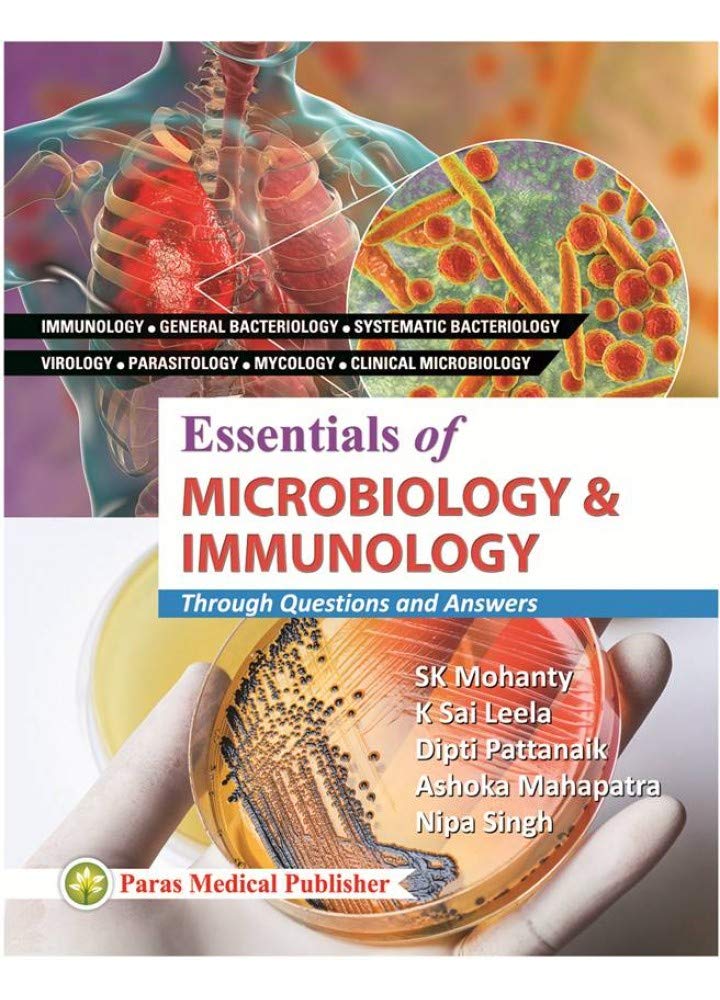
Essentials of Microbiology & Immunology : Through Questions & Answers 1st Ed 2019

Essentials of Microbiology & Immunology : Through Questions & Answers 1st Ed 2019
Essentials of Microbiology & Immunology : Through Questions & Answers 1st Ed 2019 is backordered and will ship as soon as it is back in stock.
Couldn't load pickup availability
Genuine Products Guarantee
Genuine Products Guarantee
We guarantee 100% genuine products, and if proven otherwise, we will compensate you with 10 times the product's cost.
Delivery and Shipping
Delivery and Shipping
Products are generally ready for dispatch within 1 day and typically reach you in 3 to 5 days.
Book Details
-
Publisher: Paras Medical Publishers
-
Language: English
-
Edition: First Edition (1 January 2019)
-
Pages: 714
-
Binding: Paperback
-
ISBN: 9788181915047
-
Dimensions: 20.3 × 25.4 × 4.7 cm
About the Book
This First Edition publication from Paras Medical Publishers offers an extensive and well-structured academic foundation for students and professionals in the medical field. With 714 pages of clear explanations, detailed illustrations, and updated theoretical insights, the book is crafted to support exam preparation, classroom learning, and clinical understanding. Its large-format dimensions make reading comfortable, providing a comprehensive learning experience for readers seeking accuracy and depth in their subject.